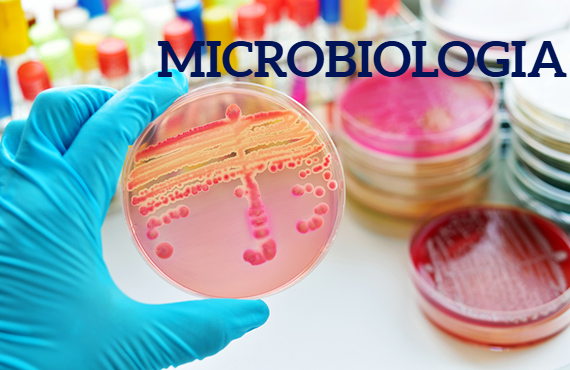
https://0201.nccdn.net/1_2/000/000/0aa/0b5/imagen15.png

LABORATORIO DE ANÁLISIS CLÍNICOS DOBLE "A"
LABORATORIO DE ANÁLISIS CLÍNICOS DOBLE "A" se especializa en proporcionar servicios de análisis clínicos con los más altos estándares de calidad, asegurando resultados precisos y confiables en cada procedimiento. Nos complace nuestra capacidad de contribuir positivamente a la salud de nuestros pacientes.